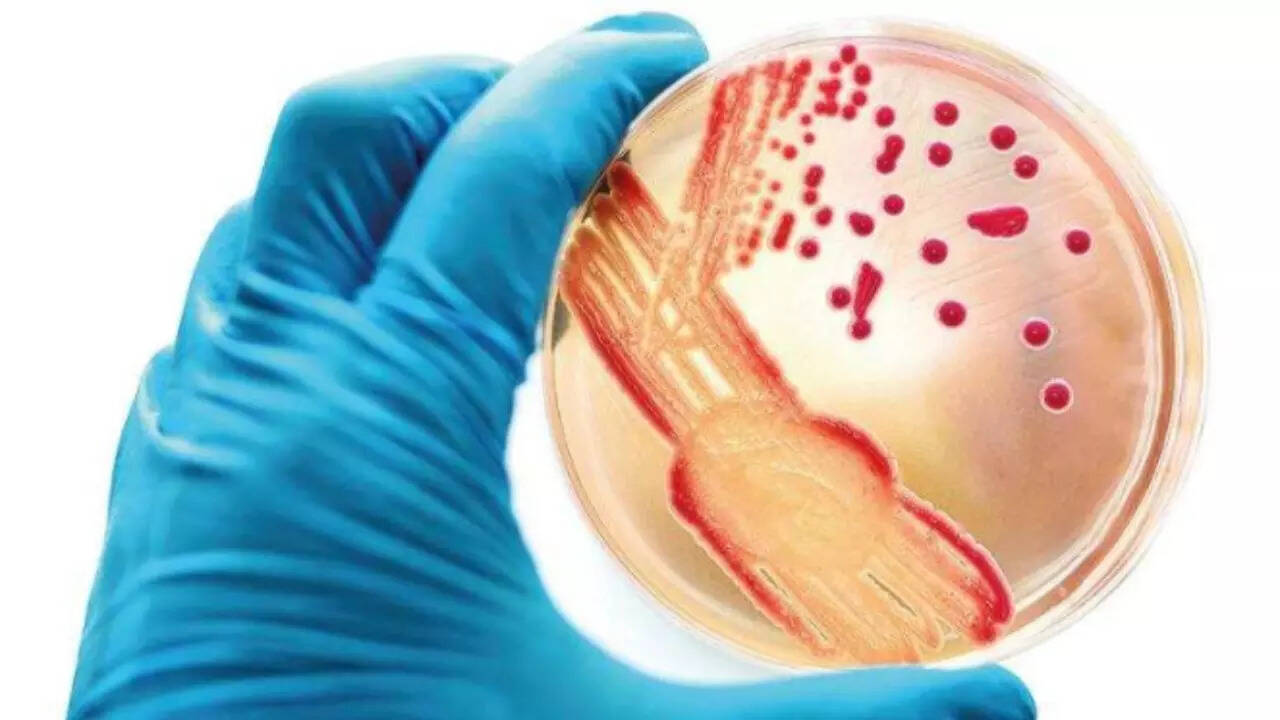

Ecoli most common mutation in ICU patients: ICMR report
More than 50% of the ICU patients battling a type of pneumonia caused by bacteria Klebsiella pneumoniae will not respond to powerful antibiotics called carbapenem. Another antibiotic, imipenem, will not affect a mutated form of Ecoli in three out of 10 cases.
More than 50% of the ICU patients battling a type of pneumonia caused by bacteria Klebsiella pneumoniae will not respond to powerful antibiotics called carbapenem. Another antibiotic, imipenem, will not affect a mutated form of Ecoli in three out of 10 cases.from Mumbai News: Latest Mumbai News Headlines & Coronavirus News Updates from Mumbai - Times of India https://ift.tt/3h1wh82
via IFTTT


No comments